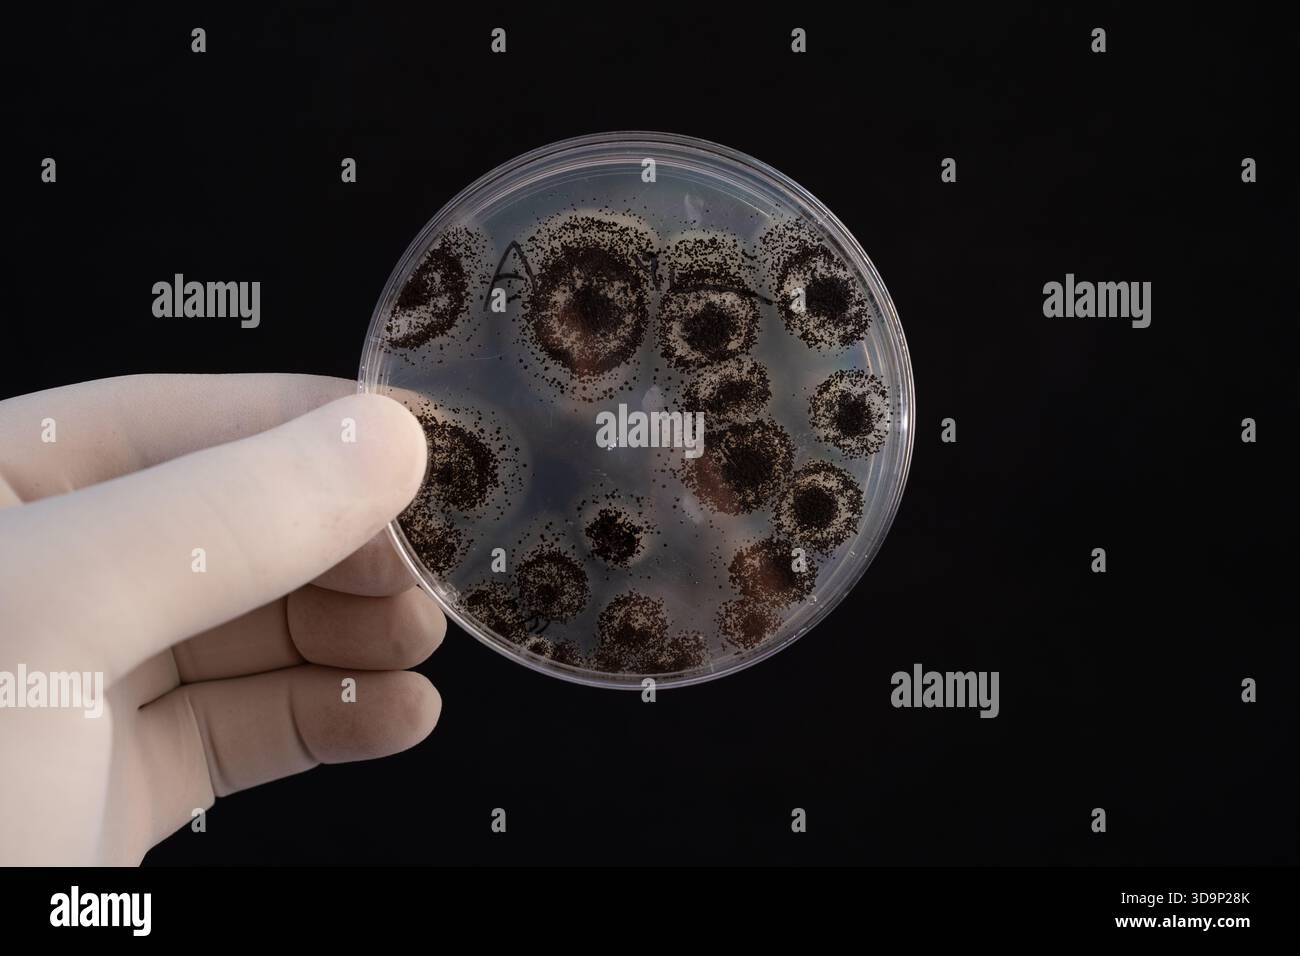
Petri Dish Culture of Aspergillus niger 🔬 mostra strutture riproduttive scure in un laboratorio di ricerca controllato. Foto Stock
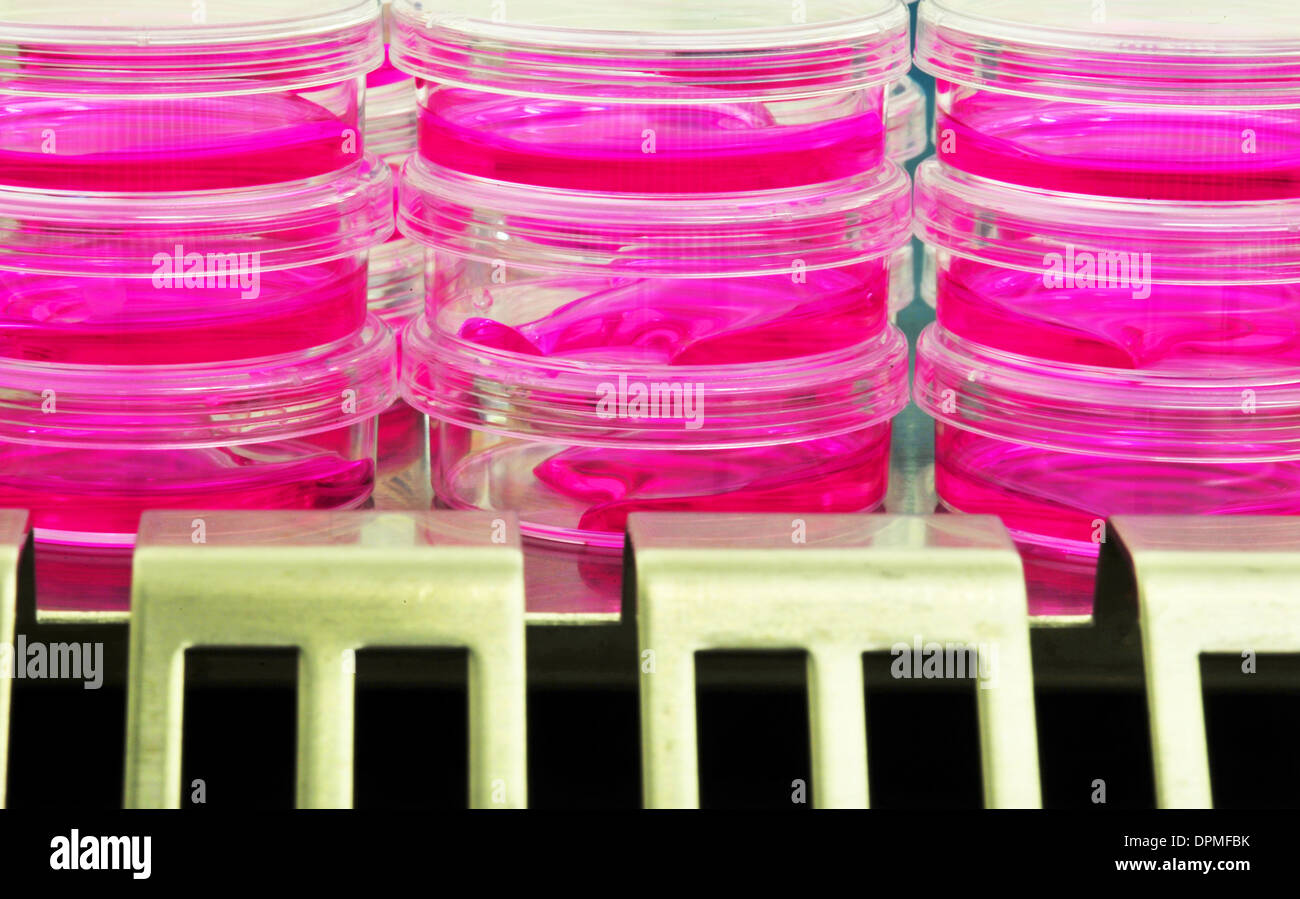
capsule di Petri Foto Stock
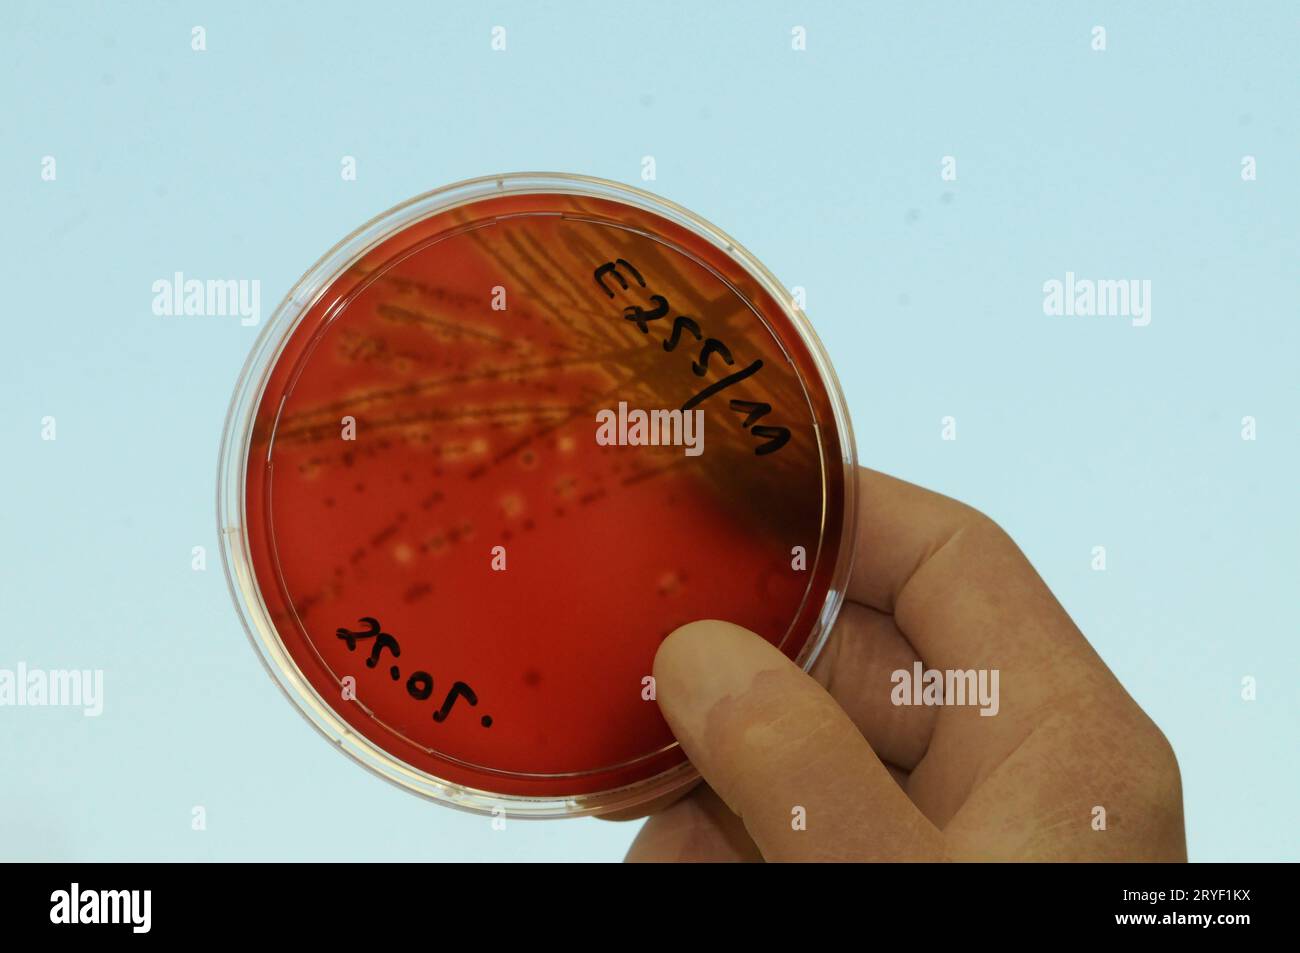
Ricerca sulla cultura cellulare condotta da uno scienziato Foto Stock

Cellula di coltura Immagini Stock
(30,905)Filtri rapidi:
Cellula di coltura Immagini Stock

RM2BE0HBJ–Micrografia leggera della cellula di coltura tissutale dal cuore di pollo. Ingrandimento 4500x.

RF2JKWMX4–Ricerca nella terapia cellulare: Ottenimento e differenziazione delle cellule staminali embrionali.

RFPG71XP–La ricerca sulle cellule staminali, scienziato tenendo una cultura jar con un gel di DNA in background

RFT8487H–Donna scienziato esaminando le cellule nel mezzo di crescita in multi piastra ben sotto microscopio in laboratorio

RFK4E55F–Il lavoro di laboratorio presso una banca sterile. La divisione di una cella in una coltura cellulare in pallone.

RFGJ3BAG–Donna scienziato esaminando le colture cellulari che cresce in un vaso di coltura in laboratorio

RMKY9PJB–Fotografia della Frontier Fiesta dell'Università di Houston negli anni '1950 che mostra gli studenti in una finta attrazione cellulare della prigione, illustrando le festività del campus, la partecipazione degli studenti e la cultura dell'intrattenimento.

RFP8RC00–Cellule che crescono in una coltura di tessuto piatto Petri isolati su sfondo nero. La mitosi, il processo di divisione cellulare e la moltiplicazione. Medicina Scientif

RFKYTYD8–Background scientifico: sfocato interno della moderna cultura cellulare camera in laboratorio moderno. Questo è defocalizzata immagine di sfondo, nessun punto di messa a fuoco qui. Ide

RF2JKWRKB–Differenziazione delle cellule staminali ottenute da un embrione sviluppato allo stadio blastocista.

RF3BDCW9A–Smistamento cellulare con pinzette ottiche. Utilizzo di trappole ottiche basate su laser per isolare e manipolare singole cellule in coltura. Tecnologie per colture cellulari.

RF2BB67CA–Illustrazione del Capitano Dreyfus nella cella di prigione di hus intitolata 'Alfred Dreyfus dans sa Prison' di Lionel Reyer pubblicato nel gennaio 1895.

RFT5FJ00–Le cellule staminali rosso coltivato terreno di crescita in un vaso di coltura con l'immagine del microscopio della struttura di cella in background

RFT8487C–Donna scienziato esaminando le cellule nel mezzo di crescita in multi piastra ben sotto microscopio in laboratorio

RFGJ3BAF–Donna scienziato esaminando le colture cellulari che cresce in un vaso di coltura in laboratorio

RMH8P4AD–La NASA Stazione Spaziale Internazionale astronauta Kate Rubins opere sulla microgravità cell cultura e ricerca in laboratorio a bordo della ISS Settembre 13, 2016 in orbita intorno alla terra.

RFP8RBYN–Cellule che crescono in una coltura di tessuto piatto Petri isolati su sfondo nero. La mitosi, il processo di divisione cellulare e la moltiplicazione. Medicina Scientif
RF3D9P28K–Petri Dish Culture of Aspergillus niger 🔬 mostra strutture riproduttive scure in un laboratorio di ricerca controllato.

RF2ATE08J–Scienziato che esamina le fiasche per colture di tessuti da un incubatore a CO2 in laboratorio

RF2BGJP51–Batteriologia gram negativo batteri coltura e penicillina muschio in vetreria Petri, vista dall'alto. Set vettoriale di batterio, microbi microbiologici, cellule germinali, illustrazione di infezione microbica

RF2JKWRJT–Differenziazione delle cellule staminali ottenute da un embrione sviluppato allo stadio blastocista.

RM2BE0J6X–TEM a colorazione negativa mostra 1918 virioni influenzali ricreati che sono stati raccolti dal supernatante di una coltura cellulare di rene di canina di Madin-Darby 1918-infetta, 18 ore dopo l'infezione. Dr.Terrence Tumpey, microbiologo del personale e membro del NCID, ha ricreato il virus influenzale del 1918 per identificare le caratteristiche che hanno reso questo organismo un patogeno mortale. Sforzi di ricerca come questo consentono ai ricercatori di sviluppare nuovi vaccini e trattamenti per i futuri virus dell'influenza pandemica. Ingrandimento sconosciuto.

RFT5JN7Y–Le cellule staminali rosso coltivato terreno di crescita in un vaso di coltura con l'immagine del microscopio della struttura di cella in background

RFT8487M–Donna scienziato esaminando le cellule nel mezzo di crescita in multi piastra ben sotto microscopio in laboratorio

RFGJ3BAD–Donna scienziato esaminando le colture cellulari che cresce in un vaso di coltura utilizzando un microscopio invertito in laboratorio

RMB8XBJ5–Piastre per colture cellulari, Istituto di Ricerche Farmacologiche Mario Negri di Milano, Italia

RMM99WNE–Cellhouse principali di ex prigione federale sull isola di Alcatraz nella Baia di San Francisco, California, Stati Uniti d'America.

RFEM8XKD–La ricerca sulle cellule staminali, il trasferimento nucleare di cellule staminali embrionali da piastra di petri usato nella clonazione per la ricerca medica

RFR0E5AR–Blastociste, illustrazione del computer. Un blastocisto è una pallina cava di cellule con un centro di fluido formata dopo varie divisioni di una cella fecondate (zigote). La massa cellulare interna (viola) contiene le celle che formano l'embrione giusto, le cellule staminali embrionali (CES).

RM2BE0J7T–TEM con colorazione negativa mostra 1918 virioni influenzali ricreati che sono stati raccolti dal supernatante di una coltura cellulare di rene di canina Madin-Darby (MDCK) infettata con 1918, 18 ore dopo l'infezione. Per sequestrare questi virioni, le cellule MDCK sono state centrifugate (centrifugazione), e il virus 1918 presente nel fluido è stato fissato per la colorazione negativa. Il Dr. Terrence Tumpey, microbiologo del personale e membro del Centro Nazionale per le malattie infettive (NCID), ha ricreato il virus influenzale del 1918 per identificare le caratteristiche che hanno reso questo organismo un patogeno mortale. Sforzi di ricerca

RFT5JTTT–Biologo cellulare visualizzazione di cellule staminali coltivate red terreno di crescita in un vaso di coltura con l'immagine del microscopio della struttura di cella in background

RFF0AB2N–La cella femmina biologo azienda pallone contenente cellule staminali, coltivato in rosso medium di crescita

RMC26J6T–Fiasche per colture cellulari e di capsule di petri in scienza lab laboratorio di microbiologia

RFGJ3BAE–Donna scienziato esaminando le colture cellulari che cresce in un vaso di coltura utilizzando un microscopio invertito in laboratorio

RMTA3M4C–Donne vestite di kimono che scattano foto di fronte al cancello di Kaminarimon, Asakusa Tokyo JP

RMB8XBJR–Fiasche per colture cellulari, Istituto di Ricerche Farmacologiche Mario Negri di Milano, Italia

RMD4P82E–Cella di contenimento alla ex sovietica NKVD speciale Berlin-Hohenschoenhausen camp, Germania

RMM99WNC–Giardini prigioniero sull isola di Alcatraz nella Baia di San Francisco, California, Stati Uniti d'America. Isola di Alcatraz ospita un carcere abbandonato ed è ora un museo.

RMPDWBCA–San Girolamo nella cella del XVI secolo da Quinten Massys (1465/66 Lions - 1530 Anversa) belga, Belgio, fiammingo, la, Olandese,

RFR0E5AW–Blastociste, illustrazione del computer. Un blastocisto è una pallina cava di cellule con un centro di fluido formata dopo varie divisioni di una cella fecondate (zigote). La massa cellulare interna (viola) contiene le celle che formano l'embrione giusto, le cellule staminali embrionali (CES).

RMH8NBNP–La NASA Stazione Spaziale Internazionale astronauta Kate Rubins opere sulla microgravità cell cultura e ricerca in laboratorio a bordo della ISS Luglio 27, 2016 in orbita intorno alla terra.

RFT5J43C–Biologo cellulare visualizzazione di cellule staminali coltivate red terreno di crescita in un vaso di coltura con l'immagine del microscopio della struttura di cella in background

RFE5WR55–Una micropipetta di precisione è utilizzato per il trasferimento di un terreno di coltura cellulare (DMEM) ad una piastra multi-pozzetto

RMC26J6B–Fiasche per colture cellulari e di capsule di petri in scienza lab laboratorio di microbiologia

RFEM8XKB–La ricerca sulle cellule staminali, il trasferimento nucleare di cellule staminali embrionali usato nella clonazione per la ricerca medica

RFF0AB2K–La cella femmina biologo azienda pallone contenente cellule staminali, coltivato in rosso medium di crescita

RMD4P7X2–Cella di contenimento alla ex sovietica NKVD speciale Berlin-Hohenschoenhausen camp, Germania

RFP8RC08–Cellule che crescono in una coltura di tessuto nella scatola di Petri. Morbido stringhe di DNA sullo sfondo. Medico scientifico il concetto di ricerca

RMH610WF–San Girolamo nella sua cella 1545 Marinus Claeszoon van Reymerswaele (c.1490-c.1546) è stato un pittore olandese Paesi Bassi

RF2JKWMYM–Ricerca nella terapia cellulare: Ottenimento e differenziazione delle cellule staminali embrionali.